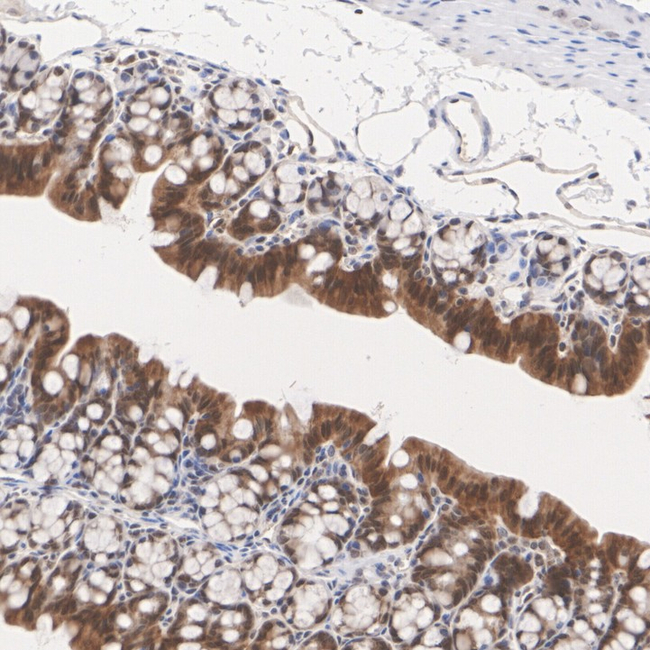
Caspase 7 Antibody in Immunohistochemistry (Paraffin) (IHC (P))

Search
Invitrogen
Caspase 7 Recombinant Rabbit Monoclonal Antibody (PSH13-69)
{{$productOrderCtrl.translations['antibody.pdp.commerceCard.promotion.promotions']}}
{{$productOrderCtrl.translations['antibody.pdp.commerceCard.promotion.viewpromo']}}
{{$productOrderCtrl.translations['antibody.pdp.commerceCard.promotion.promocode']}}: {{promo.promoCode}} {{promo.promoTitle}} {{promo.promoDescription}}. {{$productOrderCtrl.translations['antibody.pdp.commerceCard.promotion.learnmore']}}
图: 1 / 4
Caspase 7 Antibody (MA570011) in IHC (P)




Please note: We are reviewing Western blot images included in the antibody testing data in our catalog, including those provided by third parties. Unless expressly labeled or annotated as “raw-unedited”, Western blot images included in the antibody testing data in our catalog may have been edited, optimized or otherwise adjusted for presentation.
产品信息
MA570011
种属反应
宿主/亚型
Expression System
分类
类型
克隆号
抗原
偶联物
形式
浓度
规格
纯化类型
保存液
内含物
保存条件
运输条件
产品详细信息
Positive control: HeLa cell lysate, HeLa treated with 1µM staurosporine for 3 hours cell lysate, C2C12 cell lysate, C2C12 treated with 1µM staurosporine for 3 hours cell lysate, human colon tissue, mouse colon tissue, rat colon tissue.
Subcellular location: Cytoplasm, cytosol, Nucleus, Secreted, extracellular space.
靶标信息
Caspase 7 is part of a family of cysteine proteases that can be divided into the apoptotic and inflammatory caspase subfamilies. Unlike the apoptotic caspases, members of the inflammatory subfamily are generally not involved in cell death but are associated with the immune response to microbial pathogens. The apoptotic subfamily can be further divided into initiator caspases, which are activated in response to death signals, and executioner caspases, which are activated by the initiator caspases and are responsible for cleavage of cellular substrates that ultimately lead to cell death. Caspase 7 is an executioner caspase that was identified based on its homology with caspases 1 and 3, as well as the C. elegans cell death protein CED-3. Alternative splicing of Caspase-7 mRNA results in the production of 3 distinct isoforms. Caspase-7 activity can be directly inhibited by XIAP expression. Alternative splicing results in four transcript variants, encoding three distinct isoforms of Caspase 7. Diseases associated with CASP7 include Type 1 Diabetes Mellitus 17 and Aleutian Mink Disease.
仅用于科研。不用于诊断过程。未经明确授权不得转售。
篇参考文献 (0)
生物信息学
蛋白别名: Apoptotic protease Mch-3; CASP-7; Caspase-7; CMH-1; Cysteine protease LICE2; ICE-LAP3; ICE-like apoptotic protease 3; OTTHUMP00000020511; OTTHUMP00000020513; OTTHUMP00000020514; RP11-211N11.6
基因别名: AI314680; CASP7; caspase-7; CMH-1; ICE-IAP3; Lice2; mCASP-7; MCH3
UniProt ID: (Mouse) P97864
Entrez Gene ID: (Rat) 64026, (Mouse) 12369